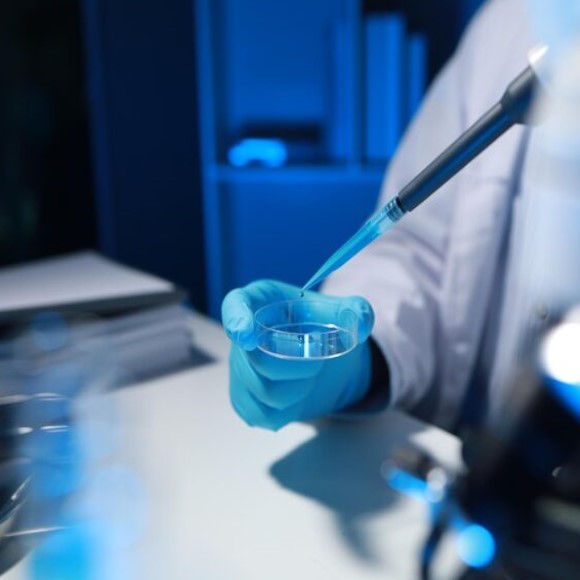

Accurate laboratory testing plays a decisive role in product integrity, regulatory approval, and long-term commercial success. The Ingredients Processing Corporation’s Analytical Laboratory delivers dependable, high-precision analytical results that support informed decision-making across regulated and performance-driven industries.
Whether analytical support is required as part of a broader ingredients processing project or as an independent laboratory service, our analytical team is equipped to meet your testing needs with consistency and speed.
Supporting trace analysis, authenticity verification, and quality evaluation
- Detection and quantification of trace and heavy metals
- Verification of food origin and ingredient authenticity
- Assessment of contamination risks and impurity levels
- Nutritional composition analysis to support labeling requirements
Serving aerospace, coatings, engineering, and high-performance sectors
- Chemical composition analysis for specialized industrial applications
- Polymer structure evaluation and performance testing
- Battery and energy-storage material characterization
- Quality verification for advanced and engineered materials
Aligned with requirements from the EPA, FDA, and industry authorities
- Environmental testing conducted under EPA-aligned methodologies
- Food and pharmaceutical testing compliant with FDA regulations
- Support for industry-specific regulatory documentation and submissions
- Generation of certificates of analysis for audit and compliance use
Designed for formulation, quality assurance, and material performance
- Active pharmaceutical ingredient (API) identification and purity test
- Incoming raw material verification and batch consistency testing
- Stability studies and shelf-life evaluation
- Material property analysis to support product optimization
Tailored analytical solutions aligned with your materials and processes
- Development of customized analytical methods for non-standard materials
- Validation of testing procedures in line with regulatory expectations
- Evaluation and refinement of existing analytical workflows
- Method transfer assistance and implementation support
Ensuring compliance, safety, and environmental responsibility
- Water quality testing for purity and application suitability
- Environmental impact and contamination studies
- Soil, waste, and byproduct analysis for regulatory adherence
- Air monitoring and emissions testing for compliance verification